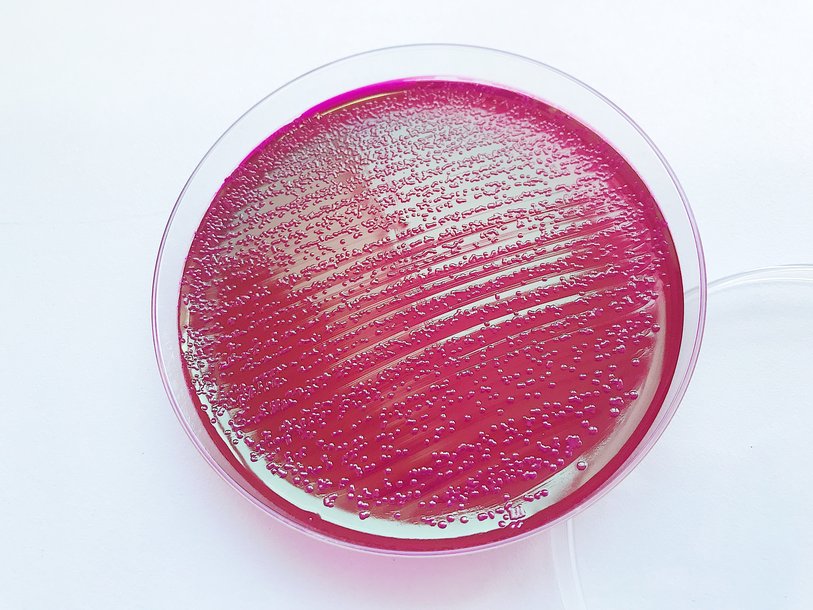

Екатерина Беленко: Промикробы: Скрытые фигуры
Clostridium difficile Фото: Екатерина Беленко
Clostridium difficile Фото: Екатерина Беленко Стоит лишь открыть чашку Петри и дать ей постоять на столе, как на ней заколосятся микроорганизмы. Да что там чашку Петри, достаточно забыть про суп в холодильнике! Но это не значит, что всех возбудителей так уж легко «культивировать». Да, есть множество неприхотливых бактерий, которым самые простые питательные среды в радость, которые счастливо растут при большом разбросе температур. Но эти микроорганизмы — лишь верхушка айсберга, а ниже — трудно выращиваемые или вовсе не культивируемые бактерии. Получается, что судить о разнообразии микробиков, учитывая только те бактерии, которые мы смогли вырастить на чашках Петри, ошибочно. И это касается как частных случаев, таких как анализ кала на дисбактериоз, так и наших общих представлений о количестве микроорганизмов на планете.
Легко поддающиеся выращиванию бактерии представляют собой лишь крохотную часть мира микробов, который существует вокруг нас. Оценки разнятся, но предполагается, что такие «невидимые», некультивируемые бактерии составляют до 99% общего числа бактерий. Большинство микроорганизмов не растут в лаборатории потому, что мы слишком мало знаем об их пищевых потребностях. Нам просто повезло, что кишечная палочка любит мясной бульон и желе из него, а стафилококк любит солененькое. Культивирование микробов — сложное дело, оно развивается методом проб и ошибок. Просто мы еще не смогли подобрать подходящее меню для скрытных ребят.
Мы не можем вырастить их на чашке Петри, но что-то же мы все-таки можем? Безусловно! Во-первых, мы можем вычислить их по ДНК, для этого достаточно знать кусочек генома искомого микроорганизма. Два известных передающихся половым путем возбудителя заболеваний — хламидии и трихомонады — категорически отказываются расти на питательных средах, их можно заметить при микроскопии или вычислить по ДНК. Во-вторых, сам микроб не нужен, если можно определить некий уникальный продукт его жизнедеятельности. Эта схема, например, работает с Clostridioides difficile.
Этот микроорганизм является анаэробом, то есть совсем не любит кислород, что создает трудности для его выращивания. C. difficile является главным возбудителем псевдомембранозного колита — тяжелого инфекционного заболевания прямой кишки, которое часто возникает в случае уничтожения флоры кишечника из-за использования антибиотиков. Симптомы заболевания могут варьироваться от легкой диареи и болей в животе до опасных для жизни воспалительных процессов, перфорации кишечника, а в тяжелых случаях — сепсиса и смерти. Эти симптомы вызваны двумя токсинами, которые, к счастью, мы умеем находить. А на основе такой «находки» врач назначит еще один антибиотик, теперь уже против клостридии, и кишечник пациента придет в норму. Так что не дисбактериозом единым... Анализ этот также выполняется из кала, его я решила не фотографировать, поэтому полюбуйтесь, как из все того же биоматериала растет кишечная палочка на среде Эндо.
Новое Татьяна Пигарева Испания от И до Я Сергей Сергеев Русское самовластие. Власть и ее границы: 1462–1917 гг. Катерина Михалева-Эгер 350 лет современной моды Леонид Чутко Сил нет Катя Колпинец Формула грез Сергей Плохий Забытые бастарды Восточного фронта Дэвид Чиверс, Том Чиверс Цифры врут. Как не дать статистике обмануть себя Пол Стейнхардт Невозможность второго рода Стивен Хоффман Пять сил, изменяющих все Уолтер Айзексон Взломавшая код Рустам Александер Закрытые. Жизнь гомосексуалов в СССР 3D-каркасы для восстановления костной ткани Платиновый бутерброд для спинтроники